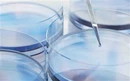
Technologia drukowania Bio 3D pomaga w leczeniu cukrzycy:...

1. For the heat dissipation of steel pipe, the inner cavity and appearance of the heat dissipation pipe of steel pipe are relatively clean. Before clean use, necessary polishing will also be carried out on the hair and pits on the steel pipe to ensure the smoothness of the track and reduce the resistance of heat flow inside the steel pipe.
2. The main advantage of copper tube heat dissipation is that it has excellent pressure resistance performance. During the process of machine loading and unloading, it has extremely strong use convenience, and also has a more beautiful appearance, which can better highlight the product value. Secondly, the overall cost of copper tube heat dissipation has a very good cost-performance advantage compared with other heat dissipation pipes. In terms of heat dissipation effect, the convection heat dissipation method is used, It can achieve obvious heat dissipation effect.
3. Aluminum alloy heat sink, aluminum alloy heat sink has a very prominent overall advantage in terms of material. Because it is made of alloy, the aluminum alloy heat sink is lighter in weight and will not increase the extra work burden of the machine. In addition, it also has a significant performance in durability. After the contact current passes, the alloy surface can generate a deadly protective film on the material surface to reduce the generation of oxidation reaction, Protect the metal from corrosion. In addition, due to the low hardness of aluminum alloy, it has a variety of use requirements in the appearance design. It can be designed into a variety of different shapes according to different scenarios, reducing the cost of production and manufacturing.